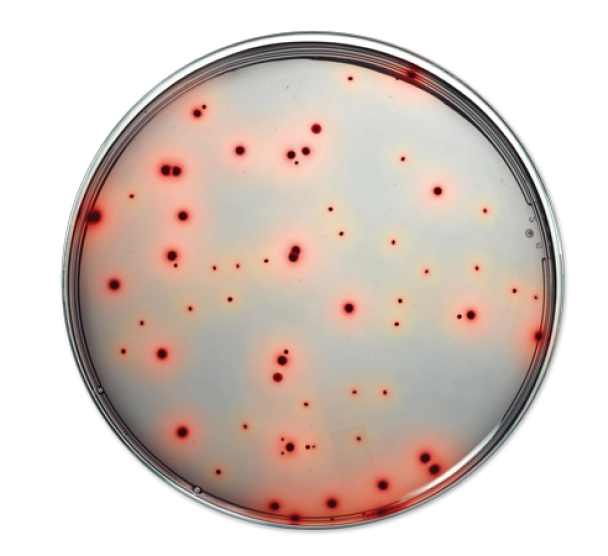
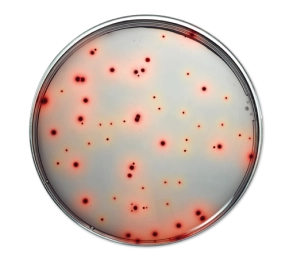
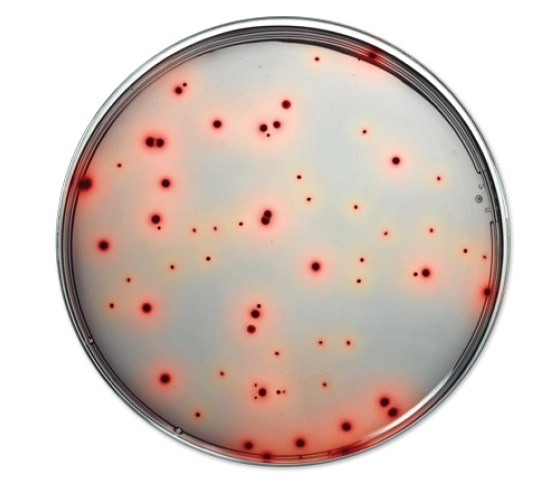

Quero conhecer os benefícios:
Entre em contato conosco hoje mesmo e descubra os benefícios do RAPID’Enterobacteriaceae da Bio-Rad.
A inovação em detecção rápida está ao seu alcance.

Resultados completos em 24 Horas
Conheça o meio de cultura cromogênico de alto desempenho para a enumeração de Enterobacteriaceae!

Transforme seus processos microbiológicos de alimentos com nossa linha inovadora.
Busca por resultados rápidos, precisos e validados internacionalmete?
Nossa solução de ponta para enumeração ágil e precisa de Enterobacteriaceae, traz mais segurança e eficiência para seus controles de qualidade.
Atenda às exigências da indústria com a rapidez que você necessita e a confiabilidade que seu cliente espera!
Resultados completos em apenas 24h sem necessidade de confirmação adicional.
Uma única placa para cada amostra, otimizando seus custos.
Colônias vermelhas de alto contraste para facilitar a identificação.
Certificação AFNOR* para enumeração, conforme a norma ISO 16140.
*Alternative analytical method for agrifood nf-validation.agnor.org/en
A flexibilidade do RAPID’Enterobacteriaceae se adapta às suas necessidades, otimizando seus processos e resultados.

Com RAPID’Enterobacteriaceae, você atende aos requisitos para a avaliação microbiológica no abate de frangos de corte.
Porque sabemos muito bem do que estamos falando! Confira você mesmo:

CARTILHA
Faça o download gratuito da cartilha e descubra como RAPID’Enterobacteriaceae valoriza seu tempo.

CURSO
Inscreva-se no curso da Universidade Bio-Rad e garanta seu certificado gratuitamente. São dois módulos repletos de conhecimentos técnicos e científicos em conceitos atuais da Segurança dos Alimentos, principalmente no nicho de análises microbiológicas, com aulas dinâmicas preparadas por experts da Bio-Rad, mestres e doutores em diferentes áreas da Ciência.

Entre em contato conosco hoje mesmo e descubra os benefícios do RAPID’Enterobacteriaceae da Bio-Rad.

Bio-Rad Brasil © Todos os direitos reservados. Política de privacidade.
| Cookie | Duração | Descrição |
|---|---|---|
| cookielawinfo-checkbox-analytics | 11 months | This cookie is set by GDPR Cookie Consent plugin. The cookie is used to store the user consent for the cookies in the category "Analytics". |
| cookielawinfo-checkbox-functional | 11 months | The cookie is set by GDPR cookie consent to record the user consent for the cookies in the category "Functional". |
| cookielawinfo-checkbox-necessary | 11 months | This cookie is set by GDPR Cookie Consent plugin. The cookies is used to store the user consent for the cookies in the category "Necessary". |
| cookielawinfo-checkbox-others | 11 months | This cookie is set by GDPR Cookie Consent plugin. The cookie is used to store the user consent for the cookies in the category "Other. |
| cookielawinfo-checkbox-performance | 11 months | This cookie is set by GDPR Cookie Consent plugin. The cookie is used to store the user consent for the cookies in the category "Performance". |
| viewed_cookie_policy | 11 months | The cookie is set by the GDPR Cookie Consent plugin and is used to store whether or not user has consented to the use of cookies. It does not store any personal data. |
Preencha o formulário e receba o material!
Preencha o formulário e receba o material!
Preencha o formulário e receba o material!